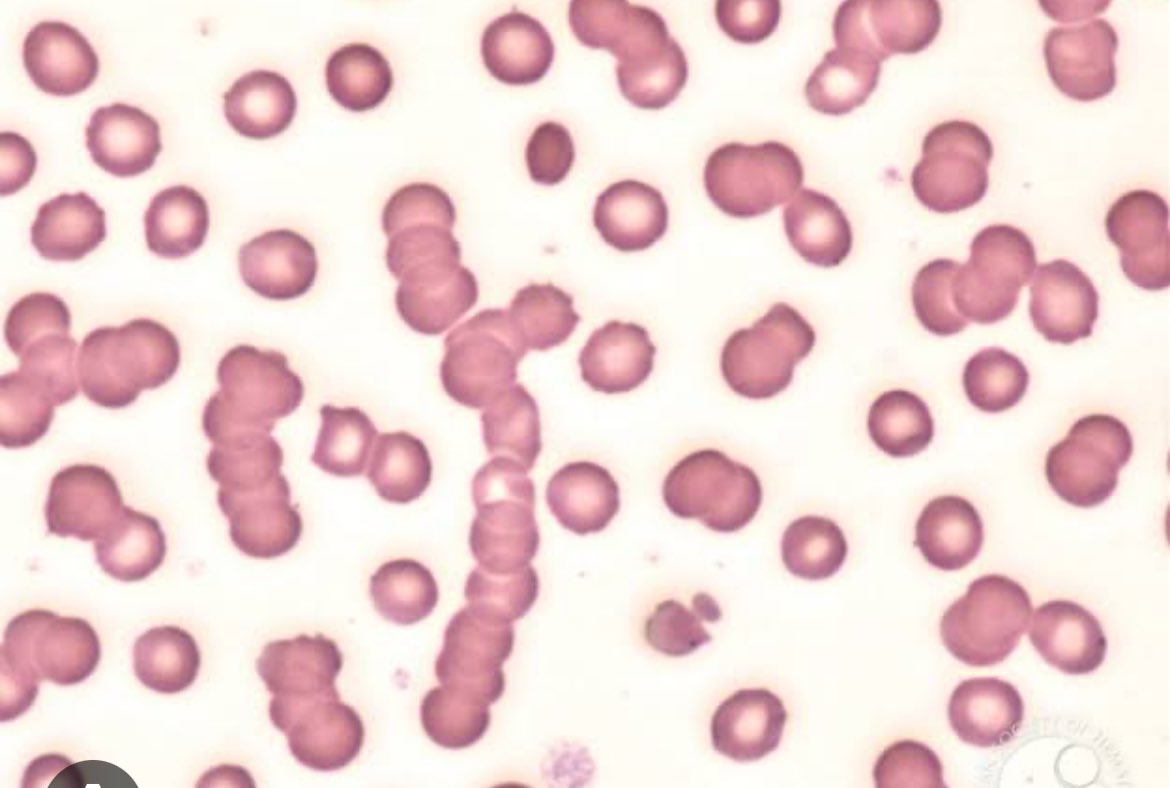
🩸🔥Why peripheral blood film is important for a nephrologist 🫘🤔

👀Look for 

✅Burr cells/echinocytes-CKD

✅Schistocytes-Microangiopathic hemolytic anemia 

✅Rouleaux-🥞look for multiple myeloma 

✅Basophilic stippling-lead poisoning 

✅Pencil ✏️cells/elliptocytes-Iron

Gowri shankar
@gowrish91
Nephrologist in making
#Tamil orator # Father 👨
ID: 1568738540
04-07-2013 18:04:29
20 Tweet
63 Followers
201 Following






Sanjeev Nair on Incremental hemodialysis at #ISNCON23 Indian Society of Nephrology Nice talk 👏🏼






I’m going to Int Society of Nephrology’s upcoming Space. Will you join too? #Nephtrials x.com/i/spaces/1YqKD…

PHENOMENAL Scientific advancement ❗❗❗ ♨️🔥💫🧾Stable function of xenokidney (gene edited pig 🫘) in decedent human model for 7 days ❗❗❗ 👀👇 Kidney International #NephTwitter #NephX #Nephrology #MedTwitter #MedX #NewsBreak




Feb 2025 Kidney News Clinical Trials Show Promise for Novel Treatments for IgA Nephropathy Bhadran Bose kidneynews.org/view/journals/… ASN Publications American Society of Nephrology


Thrilled to share our publication led by exceptional Sophie Claudel, MD "Cumulative Incidence of Mortality Associated with Cardiovascular-Kidney-Metabolic Syndrome"journals.lww.com/jasn/abstract/… in #JASN ASN Publications . We report relative and absolute risk by each CKM stages #CKM


There is no worser pain than this for a father. 😣 AMAN SHARMA 🇮🇳 Vishal Sharma Sanjeev Nair Narayanan.R (नारायणन) #PahalgamTerroristAttack